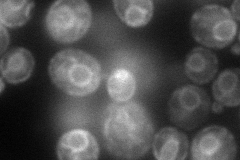
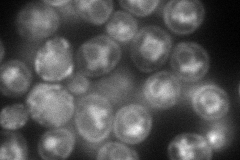
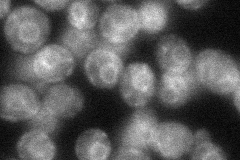
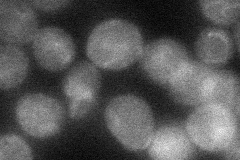

View description
Amino acid transport protein for valine, leucine, isoleucine, and tyrosine, low-affinity tryptophan and histidine transporter; overexpression confers FK506 and FTY720 resistance
Localization:
Intensity:
Fold change:
Significance:
-
C’ GFP library in SD

cell periphery100.99 -
N' NOP1pr-GFP in SD
cell periphery,ER99.0777 -
N' TEF2pr-mCherry in SD
cell periphery,ER,vacuole84.2865 -
N' NATIVEpr-GFP in SD
ER41.8943 -
N' TEF2pr-VC and Cyto-VN in SD
cell periphery38.2287 -
C’ GFP library in SD+DTT

cell periphery41.870.41Yes -
C’ GFP library in SD+H2O2

cell periphery53.350.52Yes -
C’ GFP library in Starvation Media

cytosol18.370.18No -
C’ GFP library on the background of Pup2-DaMP

cell periphery -
C’ GFP library on the background of CCT mutant

cell periphery79.19190.784104No
